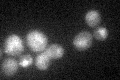
YPL006W
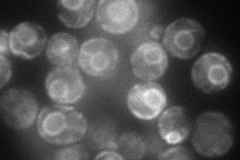
YPL006W
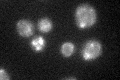
YPL006W

View description
Vacuolar membrane protein that transits through the biosynthetic vacuolar protein sorting pathway, involved in sphingolipid metabolism; glycoprotein and functional orthologue of human Niemann Pick C1 (NPC1) protein
Localization:
Intensity:
Fold change:
Significance:
-
C’ GFP library in SD
vacuole membrane22.64 -
N' NOP1pr-GFP in SD
ER94.718 -
N' TEF2pr-mCherry in SD

ER,vacuole0 -
N' NATIVEpr-GFP in SD

ambiguous,ER20.7422 -
N' TEF2pr-VC and Cyto-VN in SD

#N/A0 -
C’ GFP library in SD+DTT

vacuole membrane28.331.25No -
C’ GFP library in SD+H2O2

vacuole membrane23.231.02No -
C’ GFP library in Starvation Media
vacuole membrane41.671.84Yes -
C’ GFP library on the background of Pup2-DaMP

N/A -
C’ GFP library on the background of CCT mutant

N/A0N/AYes
